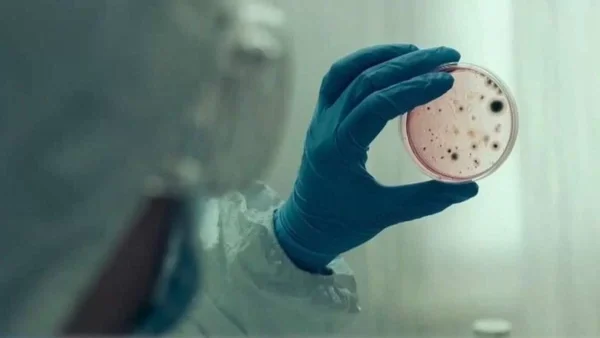
Κορωνοϊός: Tα κρούσματα στην χώρα μας για αυτή την εβδομάδα - Στα ύψη παραμένει ο αριθμός

06.11.2022 | 15:27

Η λοίμωξη με κορωνοϊό είναι μια μεταδοτική ασθένεια του αναπνευστικού συστήματος που προκαλείται από τον ιό SARS-CoV-2 ( severe acute respiratory syndrome coronavirus 2). O ιός αυτός εντοπίστηκε για πρώτη φορά το 2019 στην Κίνα στην πόλη Wuhan. Ο Παγκόσμιος Οργανισμός Υγείας ανακήρυξε την λοίμωξη από κορωνοϊό πανδημία στις 11/3/2020.